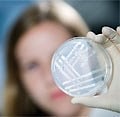

Система индентификации и классификации микроорганизмов MALDI Biotyper
 MALDI Biotyper — это быстрая и надежная система для идентификации микроорганизмов. Технологии MALDI Biotyper позволяют идентифицировать как бактерии (грамм-положительные, грамм-отрицательные), так и дрожжи, а так же многоклеточные грибы без каких либо предварительных работ.
MALDI Biotyper — это быстрая и надежная система для идентификации микроорганизмов. Технологии MALDI Biotyper позволяют идентифицировать как бактерии (грамм-положительные, грамм-отрицательные), так и дрожжи, а так же многоклеточные грибы без каких либо предварительных работ.Анализ проходит в одну стадию, и за несколько минут вы получаете исчерпывающий результат.
MALDI Biotyper применяется для медицинского контроля, пищевого и ветеринарного, а так же в микробиологических лабораториях для идентификации микроорганизмов.
MALDI Biotyper - это компактный и надежный настольный прибор нового поколения для идентификации микроорганизмов от Bruker Daltonics, преимущества которого:
- простая пробоподготовка;
- быстрота;
- надежность;
- точность и воспроизводимость;
- 105 клеток достаточно для высокоточной идентификации;
- идентификация происходит по протеому методом «отпечатка пальца»;
- работа с базой данных «Ready-to-Go»;
- доступное программное обеспечение;
- математическая обработка с применение кластерного анализа.
База данных «Ready-to-Go»
MALDI Biotyper укомплектован постоянно обновляющейся библиотекой, содержащей тысячи спектров индивидуальных штаммов. Система легко пополняема новыми данными, служащими для идентификации бактерий, дрожжей, грибов. Вы можете просмотреть часть тех микроорганизмов, спектры которых уже имеются в базе данных.
MALDI Biotyper укомплектован постоянно обновляющейся библиотекой, содержащей тысячи спектров индивидуальных штаммов. Система легко пополняема новыми данными, служащими для идентификации бактерий, дрожжей, грибов. Вы можете просмотреть часть тех микроорганизмов, спектры которых уже имеются в базе данных.Дополнительная информация и технические характеристики MALDI Biotyper.
Список пользователей MALDI Biotyper.
производитель
Bruker
метки
Микробиология
Если вы хотите купить система индентификации и классификации микроорганизмов MALDI Biotyper , вы можете:

 Аванта и К
Аванта и К
